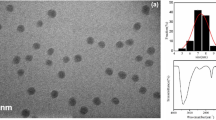

Abstract
Urchin-like In2S3 nanostructures were functionalized with multi-walled carbon nanotubes (MWCNTs) and deposited on a glassy carbon electrode (GCE) to obtain a new kind of sensor for dopamine (DA). The new electrode was characterized using scanning electron microscopy, energy dispersive X-ray spectroscopy, cyclic voltammetry and differential pulse voltammetry. It is found that the current response toward DA is significantly enhanced compared to that of a bare GCE or a GCE modified with MWCNTs. The peak separation between DA and ascorbic acid (AA) is up to 225 mV. The new electrode also has improved selectivity for DA over AA compared to the bare electrode. The new DA sensor has a wide linear range (0.5–300 μM), high sensitivity (594.9 μA mM−1 cm−2) and low detection limit (0.1 μM). CNTs wrapped on urchin-like nanostructures remarkable improve its electrocatalytic activity and thus provide a promising strategy to develop excellent composite materials for electrochemical sensing.

SEM images of urchin-like In2S3 (A) and Multi-walled carbon nanotubes-functionalized urchin-like In2S3 nanostructure (B)
Similar content being viewed by others
Explore related subjects
Discover the latest articles, news and stories from top researchers in related subjects.Avoid common mistakes on your manuscript.
Introduction
Dopamine (DA) as an important neurotransmitter, plays a significant role in the function of the central nervous, renal and hormonal systems [1]. Deficiency of DA is believed to be related to several diseases such as Schizophrenia, Huntington and Parkinson [2]. Electrochemical techniques for detecting dopamine (DA) have received considerable interest due to its electrochemical activity [3–6]. However, the main challenge to electrochemical detection of DA is its very low concentration and the strong interference resulting from much higher concentration of ascorbic acid (AA) [7]. To resolve this problem, various materials such as polymer film [8–11], nanoparticles [12–18] and nanostructures [19–23], have been used to modify working electrode for developing highly sensitive and selective methods. Among these materials, carbon nanotubes, due to the remarkable electrocatalytic properties and large surface area, have attracted great attentions [24–26]. The use of carbon nanotubes for modifying electrode can improve the sensitivity of electrochemical detection [7, 27]. Moreover, carbon nanotubes have been reported to modify electrodes for detecting DA with obviously improved sensitivity [28–30].
Recently, semiconductor nanostructured materials have gained increasing interests in the electrochemical sensing fields due to excellent properties [31, 32]. In2S3 are important semiconductors with the band-gap values of 2.8 eV [33]. Due to its unique catalytic, optical, electronic and gas-sensing properties, In2S3 can be used as catalysts, luminophors, electrodes, solar cells and gas sensors [34]. Additionally, the nanostructured In2S3 often exhibits shape- and size-dependent physical and chemical properties, which are of importance and interest to scientific research [33, 34].
In this work, urchin-like In2S3 microspheres were synthesized chemically with hydrothermal method. Then multi-walled carbon nanotubes (MWCNTs) functionalized urchin-like In2S3 was prepared to develop a novel electrochemical senor for detection of DA in the presence of ascorbic acid (AA). The electrochemical properties of MWCNTs-In2S3 were investigated by cyclic voltammetry and differential pulse voltammetry. The developed MWCNTs-In2S3 composite exhibited superior electrocatalytic activity and significantly enhanced the sensitivity for DA determination. Meanwhile, MWCNTs-In2S3 composite modified glassy carbon electrode (GCE) increased peak separation between DA and AA and showed obviously improved selectivity. The designed excellent MWCNTs-In2S3 nanostructure offers a promising application in electroanalysis and biosensing.
Experimental
Chemicals and apparatus
Indium trichloride (InCl3. 4H2O), thioacetamide (TAA), DA and AA were supplied by Sinopharm Chemical Reagent Co., Ltd (China, http://sinoreagent.cn.alibaba.com). MWCNTs (≥98% purity, 60–100 nm diameter and 1–2 μm length) were purchased from Shenzhen Nanoport Co. Ltd (China, http://www.nanotubes.com.cn). Phosphate buffer solution was 0.1 M Na2HPO4 and NaH2PO4 and its pH was adjusted with H3PO4 or NaOH solutions. All other chemicals and reagents are of analytical grade and were prepared using distilled water.
All electrochemical measurements were performed on a CHI 852C electrochemical workstation (Co., CHI, USA) at room temperature using a conventional three-electrode system with a modified GCE (Φ = 3 mm) as working electrode, a platinum wire as auxiliary electrode and a saturated calomel electrode (SCE) as reference electrode. Scanning electron micrographs (SEM) and energy dispersive X-ray spectroscopy (EDX) were recorded on a Hitachi S-4800 scanning electron microscope (Japan) with an EDX attachment at an acceleration voltage of 15 kV.
Synthesis of urchin-like In2S3 nanostructure
Urchin-like In2S3 microspheres were simply synthesized according to previous method [34]. Briefly, InCl3. 4H2O (2.0 mM) and TAA (3.0 mM) powders were firstly dissolved in 30 mL water and then transferred in Teflon-lined stainless-steel autoclaves. After 2.0 mL of acetic acid (>99.5%) was added to the mixed solution, the autoclaves were sealed and maintained at 80 °C for 12 h, then cooled to room temperature. The as-formed precipitates were filtered, washed carefully with distilled water and ethanol and finally dried in air at 60 °C. Afterward, the orange red In2S3 powders were obtained.
Preparation of MWCNTs-In2S3 modified GCE
The GCE was firstly polished successively with 0.3 and 0.05 μm alumina slurry (Buhler) followed by rinsing thoroughly with distilled water, successive ultrasonication in 1:1 nitric acid, acetone and distilled water and dried in air. MWCNTs were firstly dispersed in 30% nitric acid and then refluxed for 24 h at 140 °C. The resulting suspension was centrifuged, and the sediment was washed with water until the pH reached about 7.0. Then 0.75 mL of carboxylated MWCNTs (1.0 mg L−1) were mixed by 0.25 mL of urchin-like In2S3 (1.0 mg L−1) with ultrasonication for 0.5 h. After 5.0 μL of the mixed solution was dropped on the surface of the pretreated GCE and dried in silica gel desiccators, the MWCNTs-In2S3 modified electrode was obtained.
Results and discussion
Characterizations of MWCNTs-In2S3 modified GCE
Figure 1 displays the EDX spectrum of the resulted In2S3 nanostructure. No EDX peaks resulting from the possible contaminations of Cl, N, C and O are visible, suggesting the formation of pure phase In2S3. The atomic ratio of In to S was estimated to be 40.67:50.33, which nearly accords with stoichiometric ratio of In2S3.
SEM image in Fig. 2A shows that the synthesized In2S3 microspheres. These urchin-like microspheres are constructed with about 15–30 nm arrayed nanoflakes with the diameter of about 2 μm. As seen from SEM image of MWCNTs-In2S3 in Fig. 2B, urchin-like morphology of In2S3 disappears and MWCNTs have been uniformly wrapped on the surface of urchin-like nanostructure. The MWCNTs-In2S3 composite can not only greatly increase the effective electrode surface area but also remarkable improve the electrochemical activity of MWCNTs. These features thus are beneficial to significantly enhance the sensitivity for detecting analytes.
The cyclic voltammograms (CVs) of 50 μM DA in pH 5.0 phosphate buffer solution at different modified GCEs were shown in Fig. 3. A pair of redox peaks of DA were observed at bare GCE (curve a), while In2S3 modified GCE (curve b) shows no obvious peaks, indicating that single In2S3 is not favorable to the electrocatalytic oxidation of DA. However, MWCNTs-In2S3 modified GCE exhibits a pair of remarkable and well-defined redox peaks (curve d). The anodic peak current of DA at MWCNTs-In2S3 modified GCE is 2 times larger than that at MWCNTs modified GCE (curve c) and 3 times larger than that at bare GEC, which is ascribed to the excellent electrocatalytic capability and larger surface area of MWCNTs-In2S3.
Electrochemical behavior of DA at MWCNTs-In2S3 modified GCE
Figure 4 shows the CVs of 50 μM DA in pH 5.0 phosphate buffer solution at MWCNTs-In2S3 modified electrode at different scan rates. The reduction and oxidation peak currents of DA at MWCNTs-In2S3 GCE increased linearly with the increasing scan rate from 10 to 300 mV s−1 (The linear regression equations are I pa (μA) = 0.099 v + 2.18 with a correlation coefficient of R 2 = 0.9940 and I pc (μA) = −0.082 v−0.45 with a correlation coefficient of R 2 = 0.9981). In addition, the ratio of anodic peak current to the cathodic peak current is approximately equal (I pa/I pc ≈ 1), indicating a quasi-reversible surface-controlled process. The surface coverage (Г *) of the electroactive species (DA) on surface of the modified electrode can be calculated from the charge integration of anodic peak in CVs at 50 mV s−1, according to Г * = Q/nFA, where Q is the charge consumed in the reaction, n is the number of electrons transferred, F is the Farady constant, and A is the electrode area. The separation of the peak potential (ΔE P) is 34 mV, the number of electron transferred in the electrochemical process is 2 (n ≈ 1.7 based on the formula of 59/n mV at 25 °C). The surface coverage was calculated to be 3.7 × 10−10 mol cm−2, which is close to the value of 4.18 × 10−10 mol cm−2 reported previously [21].
The influence of the pH value on the electrochemical behavior of DA on MWCNTs- In2S3 modified electrode was investigated and shown in Fig. 5. With the increase of solution pH from 2.0 to 7.0, the redox potentials of DA shifted linearly as a function of solution pH with a slope of −50.3 mV pH−1 (Inset A of Fig. 5, The linear regression equations is E p = 0.478–0.0503pH with a correlation coefficient of R 2 = 0.9978). This slope is close to the theoretical value of −59.0 mV pH−1 [20], indicating two protons and two electrons participating in the electron transfer process (As the oxidization of DA is a two-electron process). Otherwise, when increasing pH value from 2.0 to 7.0, the anodic peak current of DA reaches a maximum value at pH 5.0 (Inset B of Fig. 5). Therefore, pH 5.0 phosphate buffer solution was employed due to the more sensitive electrochemical response of DA.
Interference study from AA
For electrochemical detection of DA, the strong interference from coexisted AA must be considered because their oxidation peaks are usually overlapped. As shown in Fig. 6A, a much smaller redox peaks of DA (ΔE P = 101 mV) was observed at bare GCE (curve a), indicating the sluggish electron transfer of DA. However, DA at MWCNTs- In2S3 modified electrode (curve b) shows a pair of quasi-reversible redox peaks at 0.23 V (ΔE P = 33 mV) with remarkable enhanced oxidization current, suggesting the obviously improved electron transfer rate. In Fig. 6B, only one broad oxidization peak of AA at 0.09 V appeared at bare electrode, while a sharp oxidization peak of AA at 0.01 V was obtained at MWCNTs-In2S3 modified electrode. The MWCNTs-In2S3 modified electrode also exhibits intriguing electrocatalytic activity to AA by decreasing the over-potential and increasing the oxidization current. As can be seen form Fig. 6C, a broad and irreversible oxidization peak of the mixture of DA and AA was observed at bare electrode. However, for the MWCNTs-In2S3 modified electrode, two well separated oxidization peaks of DA and AA were obtained with the peak separation of 176 mV.
Selective detection of DA at MWCNTs-In2S3 modified GCE
Differential pulse voltammogram (DPV) of the mixture (DA + AA) (Fig. 7A) at MWCNTs-In2S3 modified electrode shows two well separated oxidization peaks with greatly increased oxidization peak currents. The peak separation of DA and DA at MWCNTs-In2S3 modified electrode is 225 mV, which is larger than that of 148 mV at bare electrode. These results indicate that MWCNTs-In2S3 modified electrode not only obviously improves the selectivity for DA toward AA but also remarkably enhances the sensitivity of DA detection.
DPV of 0.1 mM DA + 0.1 mM AA in pH 5.0 phosphate buffer solution on bare GCE (a) and MWCNTs-In2S3 GCE (b) at a scan rate of 50 mV s−1 (A) and DPVs of 0.5, 1, 5, 10, 50, 100, 200, 300, 400, 500 and 600 μM DA (from a to k) on MWCNTs-In2S3 modified GCE in pH 5.0 phosphate buffer solution, inset: calibration curve for DA (B)
The potential separation of DA and AA at MWCNTs-In2S3 modified GCE is 225 mV, which is sufficient enough for the selective determination of DA. Figure 7B shows the DPVs of different concentrations of DA. The peak currents increased linearly with the increase of DA concentration ranging from 0.5 μM to 300 μM with a low detection limit of 0.1 μM at signal-to-noise of 3 (Inset of Fig. 7B). The comparisons for the analytical performance by use of the developed and several other modified electrodes were listed in Table 1. It can be seen from Table 1, the obtained detection limit for DA is much lower than those of other electrochemical biosensors. Meanwhile, the linear range of this work was wider than that of previous methods listed in Table 1. Furthermore, the sensitivity for MWCNTs-In2S3 modified GCE was calculated to be 594.9 μA mM−1 cm−2, which is higher than that of 121.6 μA mM−1 cm−2 at carbon nanotubes modified GCE for DA [40].
Analytical application
To evaluate the potential application of MWCNTs-In2S3 modified electrode, DA in pharmaceutical product, dopamine hydrochloride injection, was determined with differential pulse voltammetry. The DA samples (65.28 μM) were obtained by diluting DA injection (10 mg mL−1) at a ratio of 1:1,000 with pH 5.0 phosphate buffer solution. The DA level was detected to be 65.51 μM close to 65.28 μM standard value with five measurements. The recovery was tested by detecting the DA standard solution spiked in the DA samples and shown in Table 2. The obtained recovery values were acceptable, indicating good accuracy for determining of DA in real samples.
Conclusions
A novel MWCNTs-In2S3 modified electrode is developed for highly efficient electrocatalytic detection of DA. Compared to the bare and MWCNTs modified GCEs, This MWCNTs-In2S3 composite has larger specific surface area and exhibits intriguing electrocatalytic activity with remarkably enhanced sensitivity for DA. The resulting electrode can separate the peak potentials of DA and AA by about 225 mV in the presence of AA and shows perfect selectivity for DA detection. The constructed DA electrochemical sensor has high sensitivity, lower detection limit and wide linear range. The MWCNTs-In2S3 composite opens a new avenue for developing promising electrochemical biosensor.
References
Heien MLAV, Khan AS, Ariansen JL, Cheer JF, Phillips PEM, Wassum KM, Wightman RM (2005) Real-time measurement of dopamine fluctuations after cocaine in the brain of behaving rats. Proc Natl Acad Sci U S A 102:10023
Wightman RM, May LJ, Michael AC (1988) Detection of dopamine dynamics in the brain. Anal Chem 60:769A
Chang JL, Wei GT, Zen JM (2011) Screen-printed ionic liquid/preanodized carbon electrode: effective detection of dopamine in the presence of high concentration of ascorbic acid. Electrochem Commun 13:174
Snowden ME, Unwin PR, Macpherson JV (2011) Single walled carbon nanotube channel flow electrode: hydrodynamic voltammetry at the nanomolar level. Electrochem Commun 13:186
Wang Y, Li YM, Tang LH, Lu J, Li JH (2009) Application of graphene-modified electrode for selective detection of dopamine. Electrochem Commun 11:889
Xiao CH, Chu XC, Yang Y, Li X, Zhang XH, Chen JH (2011) Hollow nitrogen-doped carbon microspheres pyrolyzed from self-polymerized dopamine and its application in simultaneous electrochemical determination of uric acid, ascorbic acid and dopamine. Biosens Bioelectron 26:2934
Ali SR, Ma YF, Parajuli RR, Balogun Y, Lai WYC, He HX (2007) A nonoxidative sensor based on a self-doped polyaniline/carbon nanotube composite for sensitive and selective detection of the neurotransmitter dopamine. Anal Chem 79:2583
Ciszewski A, Milczarek G (1999) Polyeugenol-modified platinum electrode for selective detection of dopamine in the presence of ascorbic acid. Anal Chem 71:1055
Jin GY, Zhang YZ, Cheng WX (2005) Poly(p-aminobenzene sulfonic acid)-modified glassy carbon electrode for simultaneous detection of dopamine and ascorbic acid. Sensors Actuators B 107:528
Kumar SA, Tang CF, Chen SM (2008) Poly(4-amino-1-1′-azobenzene-3, 4′-disulfonic acid) coated electrode for selective detection of dopamine from its interferences. Talanta 74:860
Zhang R, Jin GD, Chen D, Hu XY (2009) Simultaneous electrochemical determination of dopamine, ascorbic acid and uric acid using poly(acid chrome blue K) modified glassy carbon electrode. Sensors Actuators B Chem 138:174
Huang JS, Liu Y, Hou HQ, You TY (2008) Simultaneous electrochemical determination of dopamine, uric acid and ascorbic acid using palladium nanoparticle-loaded carbon nanofibers modified electrode. Biosens Bioelectron 24:632
Ndangili PM, Arotiba OA, Baker PGL, Iwuoha EI (2010) A potential masking approach in the detection of dopamine on 3-mercaptopropionic acid capped ZnSe quantum dots modified gold electrode in the presence of interferences. J Electroanal Chem 643:77
Shakkthivel P, Chen SM (2007) Simultaneous determination of ascorbic acid and dopamine in the presence of uric acid on ruthenium oxide modified electrode. Biosens Bioelectron 22:1680
Tang CF, Kumar SA, Chen SM (2008) Zinc oxide/redox mediator composite films-based sensor for electrochemical detection of important biomolecules. Anal Biochem 380:174
Wang YL, Nepal D, Geckeler KE (2005) Hollow porous carbon nanospheres with large surface area and stability, assembled from oxidized fullerenes. J Mater Chem 15:1049
Shaidarova LG, Chelnokova IA, Romanova EI, Gedmina AV, Budnikov GK (2011) Joint voltammetric determination of dopamine and uric acid. Russ J Appl Chem 84:218
Shaidarova LG, Chelnokova IA, Gedmina AV, Budnikov GK (2009) Simultaneous voltammetric determination of dopamine and ascorbic acid at an electrode modified with the gold-palladium binary system. J Anal Chem 64:36
EI-Said WA, Lee JH, Oh BK, Choi JW (2010) 3-D nanoporous gold thin film for the simultaneous electrochemical determination of dopamine and ascorbic acid. Electrochem Commun 12:1756
Ge PY, Du Y, Xu JJ, Chen HY (2009) Detection of dopamine based on the unique property of gold nanofilm. J Electroanal Chem 633:182
Jia Z, Liu J, Shen YB (2007) Fabrication of a template-synthesized gold nanorod-modified electrode for the detection of dopamine in the presence of ascorbic acid. Electrochem Commun 9:2739
Sun D, Xie XF, Zhang HJ (2010) Surface effects of mesoporous silica modified electrode and application in electrochemical detection of dopamine. Colloid Surf B 75:88
Sun CL, Lee HH, Yang JM, Wu CC (2011) The simultaneous electrochemical detection of ascorbic acid, dopamine, and uric acid using graphene/size-selected Pt nanocomposites. Biosens Bioelectron 26:3450
Deng SY, Jian GQ, Lei JP, Hu Z, Ju HX (2009) A glucose biosensor based on direct electrochemistry of glucose oxidase immobilized on nitrogen-doped carbon nanotubes. Biosens Bioelectron 25:373
Gao WC, Dong HF, Lei JP, Ji HX, Ju HX (2011) Signal amplification of streptavidin-horseradish peroxidase functionalized carbon nanotubes for amperometric detection of attomolar DNA. Chem Commun 47:5220
Wang J, Lin YH (2008) Functionalized carbon nanotubes and nanofibers for biosensing applications. TrAC Trends Anal Chem 27:619
Du D, Wang MH, Qin YH, Lin YH (2010) One-step electrochemical deposition of Prussian Blue-multiwalled carbon nanotube nanocomposite thin-film: preparation, characterization and evaluation for H2O2 sensing. J Mater Chem 20:1532
Adekunle AS, Agboola BO, Pillay J, Ozoemena KI (2010) Electrocatalytic detection of dopamine at single-walled carbon nanotubes-iron (III) oxide nanoparticles platform. Sensors Actuators B Chem 148:93
Hocevar SB, Wang J, Deo RP, Musameh M, Ogorevc B (2005) Carbon nanotube modified microelectrode for enhanced voltammetric detection of dopamine in the presence of ascorbate. Electroanalysis 17:417
Moreno M, Arribas AS, Bermejo E, Chicharro M, Zapardiel A, Rodriguez MC, Jalit Y, Rivas GA (2010) Selective detection of dopamine in the presence of ascorbic acid using carbon nanotube modified screen-printed electrodes. Talanta 80:2149
Dong XY, Mi XN, Zhao WW, Xu JJ, Chen HY (2011) CdS nanoparticles functionalized colloidal carbon particles: preparation, characterization and application for electrochemical detection of thrombin. Biosens Bioelectron 26:3654
Yang ZJ, Ren YY, Zhang RC, Li J, Li HB, Huang XC, Hu XY, Xu Q (2011) Nanoflake-like SnS2 matrix for glucose biosensing based on direct electrochemistry of glucose oxidase. Biosens Bioelectron 26:4337
Wang QY, Yu K, Xu F, Wu J (2008) Synthesis and field-emission properties of In2O3 nanostructures. Mater Lett 62:2710
Bai HX, Zhang LX, Zhang YC (2009) Simple synthesis of urchin-like In2S3 and In2O3 nanostructures. Mater Lett 63:823
Baldrich E, Gómez R, Gabriel G, Muñoz FX (2011) Magnetic entrapment for fast, simple and reversible electrode modification with carbon nanotubes: application to dopamine detection. Biosens Bioelectron 26:1876
Kim YR, Bong S, Kang YJ, Yang Y, Mahajan RK, Kim JS, Kim H (2010) Electrochemical detection of dopamine in the presence of ascorbic acid using graphene modified electrodes. Biosens Bioelectron 25:2366
Wang AJ, Feng JJ, Li YF, Xi JL, Dong WJ (2010) In-situ decorated gold nanoparticles on polyaniline with enhanced electrocatalysis toward dopamine. Microchim Acta 171:431
Joshi P, Joshi HC, Sanghi SK, Kundu S (2010) Immobilization of monoamine oxidase on eggshell membrane and its application in designing an amperometric biosensor for dopamine. Microchim Acta 169:383
Wang YL, Peng W, Liu L, Tang M, Gao F, Li MG (2011) Enhanced conductivity of a glassy carbon electrode modified with a graphene-doped film of layered double hydroxides for selective sensing of dopamine. Microchim Acta 174:41
Chen PY, Vittal R, Nien PC, Ho KC (2009) Enhancing dopamine detection using a glassy carbon electrode modified with MWCNTs, quercetin, and Nafion (R). Biosens Bioelectron 24:3504
Acknowledgements
This work was financially supported by from National Natural Science Foundation of China (20875081, 21075107, 21005070), The Priority Academic Program Development of Jiangsu Higher Education Institution, Projects of the 863 Plan (2009AA0Z331), Postdoctoral Science Foundation of China (20110491462), Postdoctoral Science Foundation of Jiangsu Province (1101020B) and the Open Research Fund of State Key Laboratory of Bioelectronics of Southeast University (2011E13).
Author information
Authors and Affiliations
Corresponding authors
Rights and permissions
About this article
Cite this article
Yang, Z., Huang, X., Li, J. et al. Carbon nanotubes-functionalized urchin-like In2S3 nanostructure for sensitive and selective electrochemical sensing of dopamine. Microchim Acta 177, 381–387 (2012). https://doi.org/10.1007/s00604-012-0791-8
Received:
Accepted:
Published:
Issue Date:
DOI: https://doi.org/10.1007/s00604-012-0791-8